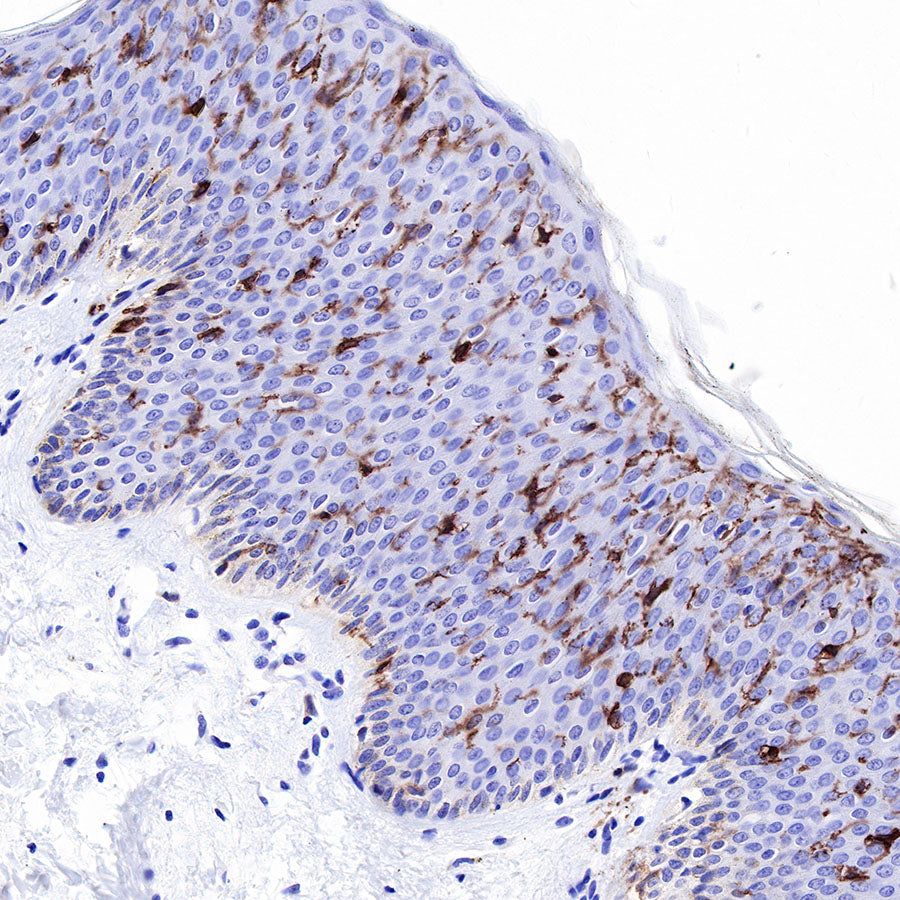
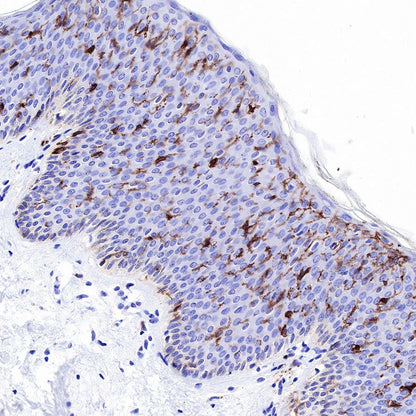

IHC shows positive staining in paraffin-embedded human cervical carcinoma. Anti-CDA1 antibody was used at 1/500 dilution, followed by a HRP Polymer for Mouse & Rabbit IgG (ready to use). Counterstained with hematoxylin. Heat mediated antigen retrieval with Tris/EDTA buffer pH9.0 was performed before commencing with IHC staining protocol.
Product Details
Product Details
Product Specification
| Host | Rabbit |
| Antigen | CD1a |
| Synonyms | CD1a, T-cell surface antigen T6, Leu-6 |
| Immunogen | N/A |
| Location | Endosome, Cell membrane |
| Accession | P06126 |
| Clone Number | SDT-R086 |
| Antibody Type | Rabbit mAb |
| Application | IHC-P |
| Reactivity | Hu |
| Purification | Protein A |
| Concentration | 0.5 mg/ml |
| Physical Appearance | Liquid |
| Storage Buffer | PBS, 40% Glycerol, 0.05%BSA, 0.03% Proclin 300 |
| Stability & Storage | 12 months from date of receipt / reconstitution, -20 °C as supplied |
Dilution
| application | dilution | species |
| IHC-P | 1:500 | null |
Background
CD1a (Cluster of Differentiation 1a) is a human protein encoded by the CD1A gene. This gene encodes a member of the CD1 family of transmembrane glycoproteins, which are structurally related to the major histocompatibility complex (MHC) proteins and form heterodimers with beta-2-microglobulin. The CD1 proteins mediate the presentation of primarily lipid and glycolipid antigens of self or microbial origin to T cells. The human genome contains five CD1 family genes organized in a cluster on chromosome 1.
Picture
Picture
Immunohistochemistry


IHC shows positive staining in paraffin-embedded human skin. Anti-CDA1 antibody was used at 1/500 dilution, followed by a HRP Polymer for Mouse & Rabbit IgG (ready to use). Counterstained with hematoxylin. Heat mediated antigen retrieval with Tris/EDTA buffer pH9.0 was performed before commencing with IHC staining protocol.

IHC shows positive staining in paraffin-embedded human esophagus. Anti--CDA1 antibody was used at 1/500 dilution, followed by a HRP Polymer for Mouse & Rabbit IgG (ready to use). Counterstained with hematoxylin. Heat mediated antigen retrieval with Tris/EDTA buffer pH9.0 was performed before commencing with IHC staining protocol.